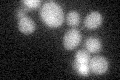
YLR188W
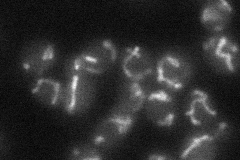
YLR188W
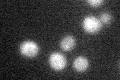
YLR188W
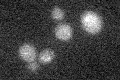
YLR188W

View description
Mitochondrial inner membrane half-type ATP-binding cassette (ABC) transporter, mediates export of peptides generated upon proteolysis of mitochondrial proteins, plays a role in the regulation of cellular resistance to oxidative stress
Localization:
Intensity:
Fold change:
Significance:
-
C’ GFP library in SD
below threshold17.43 -
N' NOP1pr-GFP in SD

mitochondria99.157 -
N' TEF2pr-mCherry in SD

missing0 -
N' NATIVEpr-GFP in SD
mitochondria22.5559 -
N' TEF2pr-VC and Cyto-VN in SD

#N/A0 -
C’ GFP library in SD+DTT
cytosol13.50.77No -
C’ GFP library in SD+H2O2

cytosol15.260.87No -
C’ GFP library in Starvation Media
cytosol15.480.88No -
C’ GFP library on the background of Pup2-DaMP

below threshold -
C’ GFP library on the background of CCT mutant

below threshold15.32790.878907No
